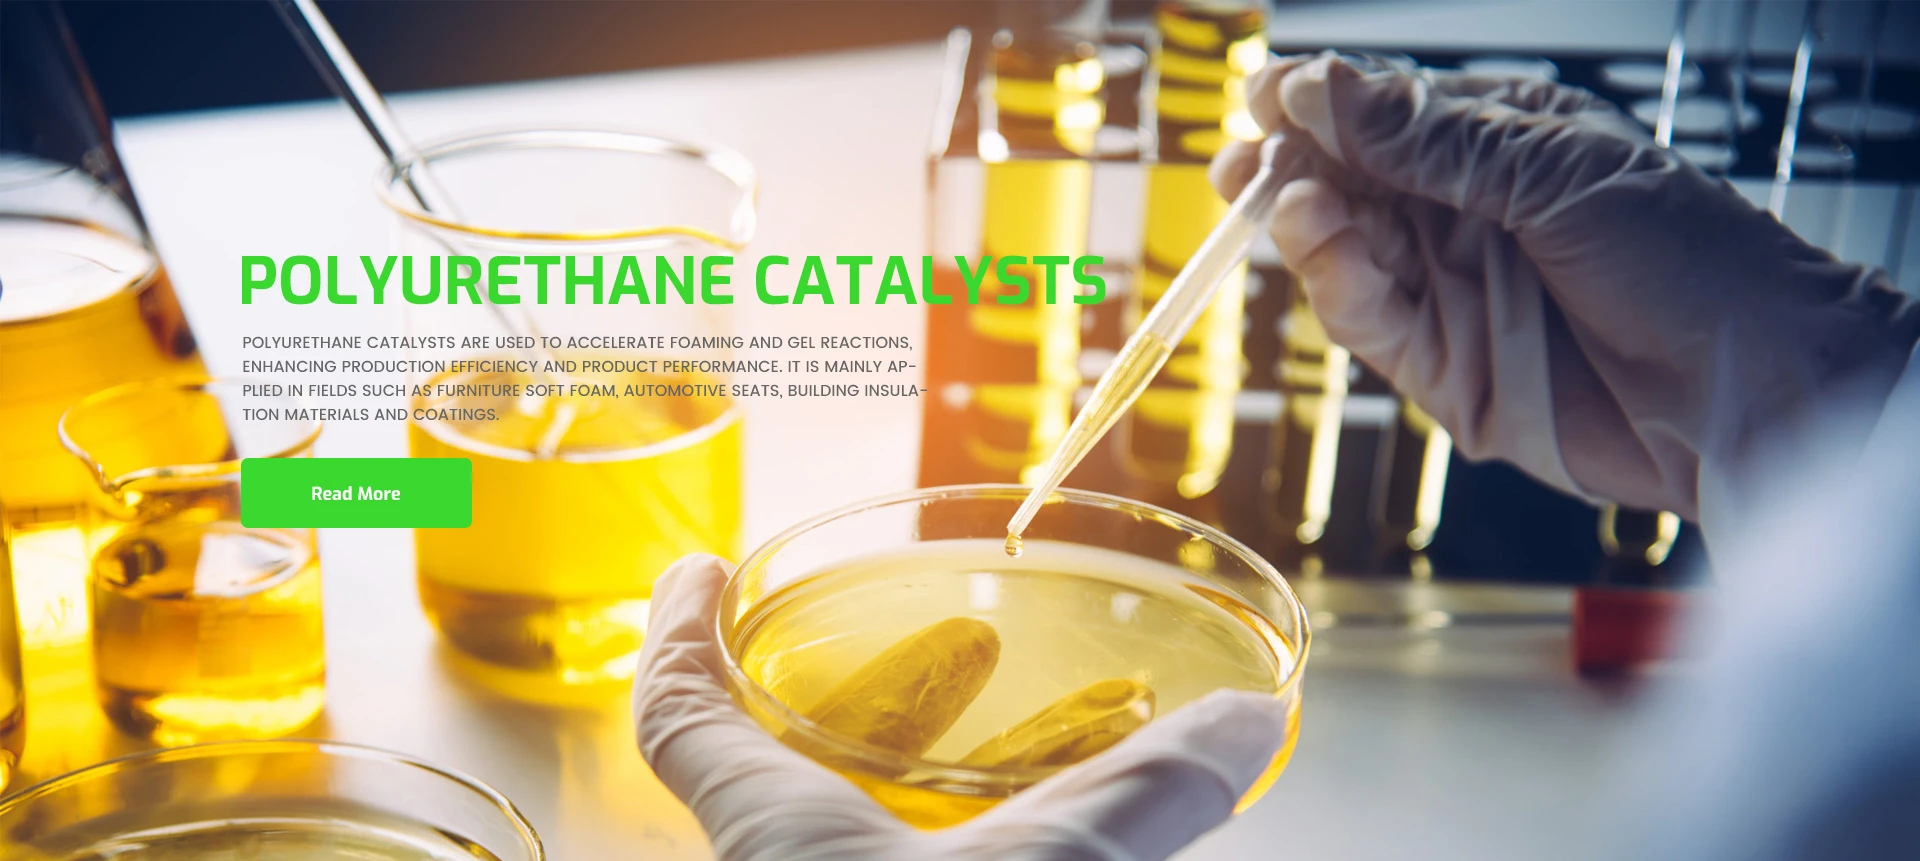
pharmaceutical product development company

Cefazolin Sodium is a first-generation cephalosporin antibiotic material primarily used for its broad-spectrum bactericidal activity against Gram-positive organisms. It is widely applied in the production of injectable antibiotics and is valued for its rapid onset and reliable pharmacokinetic properties. Cefazolin Sodium works by inhibiting bacterial cell wall synthesis and is especially effective in treating infections of the respiratory tract, skin, soft tissue, bones, joints, and urinary tract. Its sodium salt form enhances water solubility, making it ideal for sterile injectable formulations. Produced under strict GMP standards, Cefazolin Sodium ensures pharmaceutical-grade purity, stability, and safety, making it a key active pharmaceutical ingredient (API) for both clinical and surgical use.
-
1999Since
-
6Branch Office
-
900Staff
-
200Annual Income
-
 Personal CareSurfactants are essential ingredients in personal care products, such as shampoos, body washes, facial cleansers, and toothpaste. They effectively remove oil, dirt, and impurities from the skin and hair while creating a rich lather for an enjoyable user experience. Additionally, surfactants act as emulsifiers and wetting agents, improving product stability and texture to meet various skin needs and functional requirements.
Personal CareSurfactants are essential ingredients in personal care products, such as shampoos, body washes, facial cleansers, and toothpaste. They effectively remove oil, dirt, and impurities from the skin and hair while creating a rich lather for an enjoyable user experience. Additionally, surfactants act as emulsifiers and wetting agents, improving product stability and texture to meet various skin needs and functional requirements. -
 Home And I&i CleaningSurfactants are vital components in cleaning products for both household and industrial applications. They effectively break down grease, stains, and dirt, enhancing cleaning efficiency by reducing water's surface tension for deeper penetration. Whether for daily home cleaning or industrial equipment maintenance, surfactants deliver powerful and consistent performance. Their formulations can be customized to meet specific needs, such as degreasing, disinfection, or rust prevention.
Home And I&i CleaningSurfactants are vital components in cleaning products for both household and industrial applications. They effectively break down grease, stains, and dirt, enhancing cleaning efficiency by reducing water's surface tension for deeper penetration. Whether for daily home cleaning or industrial equipment maintenance, surfactants deliver powerful and consistent performance. Their formulations can be customized to meet specific needs, such as degreasing, disinfection, or rust prevention. -
 PharmaceuticalPharmaceutical intermediates and APIs (Active Pharmaceutical Ingredients) are essential components in drug manufacturing. Intermediates serve as key building blocks for API synthesis, while APIs provide therapeutic effects in final dosage forms.
PharmaceuticalPharmaceutical intermediates and APIs (Active Pharmaceutical Ingredients) are essential components in drug manufacturing. Intermediates serve as key building blocks for API synthesis, while APIs provide therapeutic effects in final dosage forms. -
 PolyurethanePolyurethane catalysts are used to accelerate foaming and gel reactions, enhancing production efficiency and product performance. It is mainly applied in fields such as furniture soft foam, automotive seats, building insulation materials and coatings.
PolyurethanePolyurethane catalysts are used to accelerate foaming and gel reactions, enhancing production efficiency and product performance. It is mainly applied in fields such as furniture soft foam, automotive seats, building insulation materials and coatings.